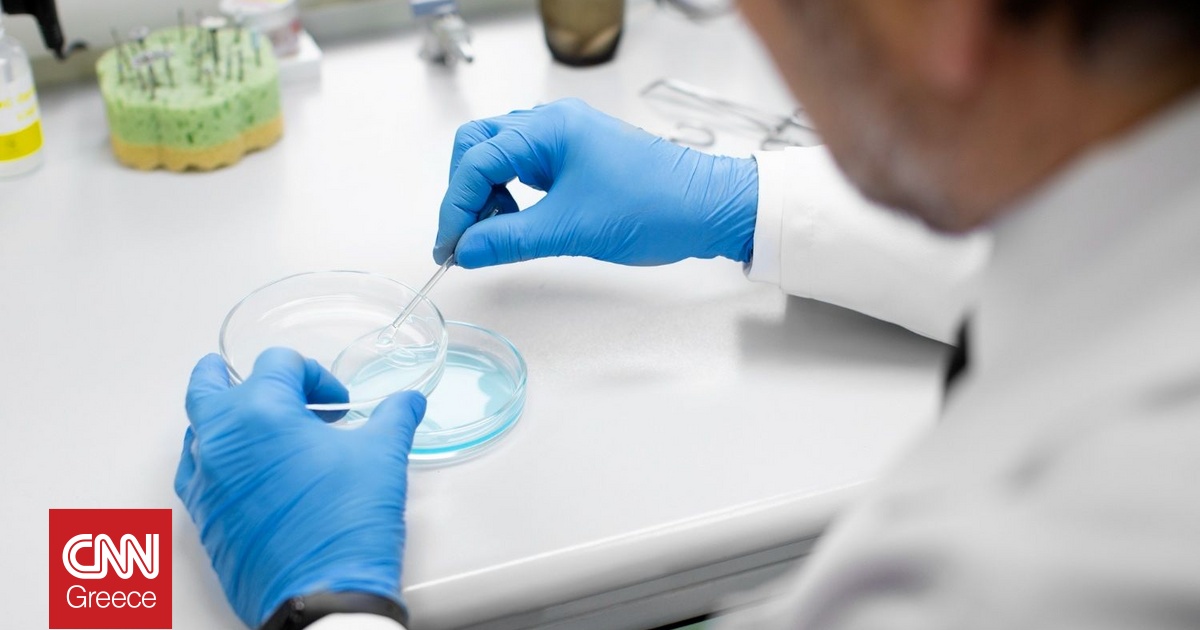
Κυτταρικές θεραπείες: Τι καινούριο φέρνουν σε σοβαρά νοσήματα – Εξηγεί ο καθηγητής Π. Τσιριγώτης

Την προσοχή των Ευρωπαίων εταίρων της Κυπριακής Δημοκρατίας έχει τραβήξει η στεγαστική πολιτική που ακολουθεί το Υπουργείο Εσωτερικών, καθώς διαπιστώθηκε πως αυτός είναι ο δρόμος που πρέπει να ακολουθεί και το ευρωπαϊκό σχέδιο για προσιτή στέγη, το οποίο αυτή τη στιγμή είναι προς διαβούλευση στα κράτη μέλη της Ευρωπαϊκής Ένωσης. Την ίδια ώρα, ο υπουργός Εσωτερικών, Κωνσταντίνος Ιωάννου, συνεχίζει τις επαφές με ομολόγους του, σε…